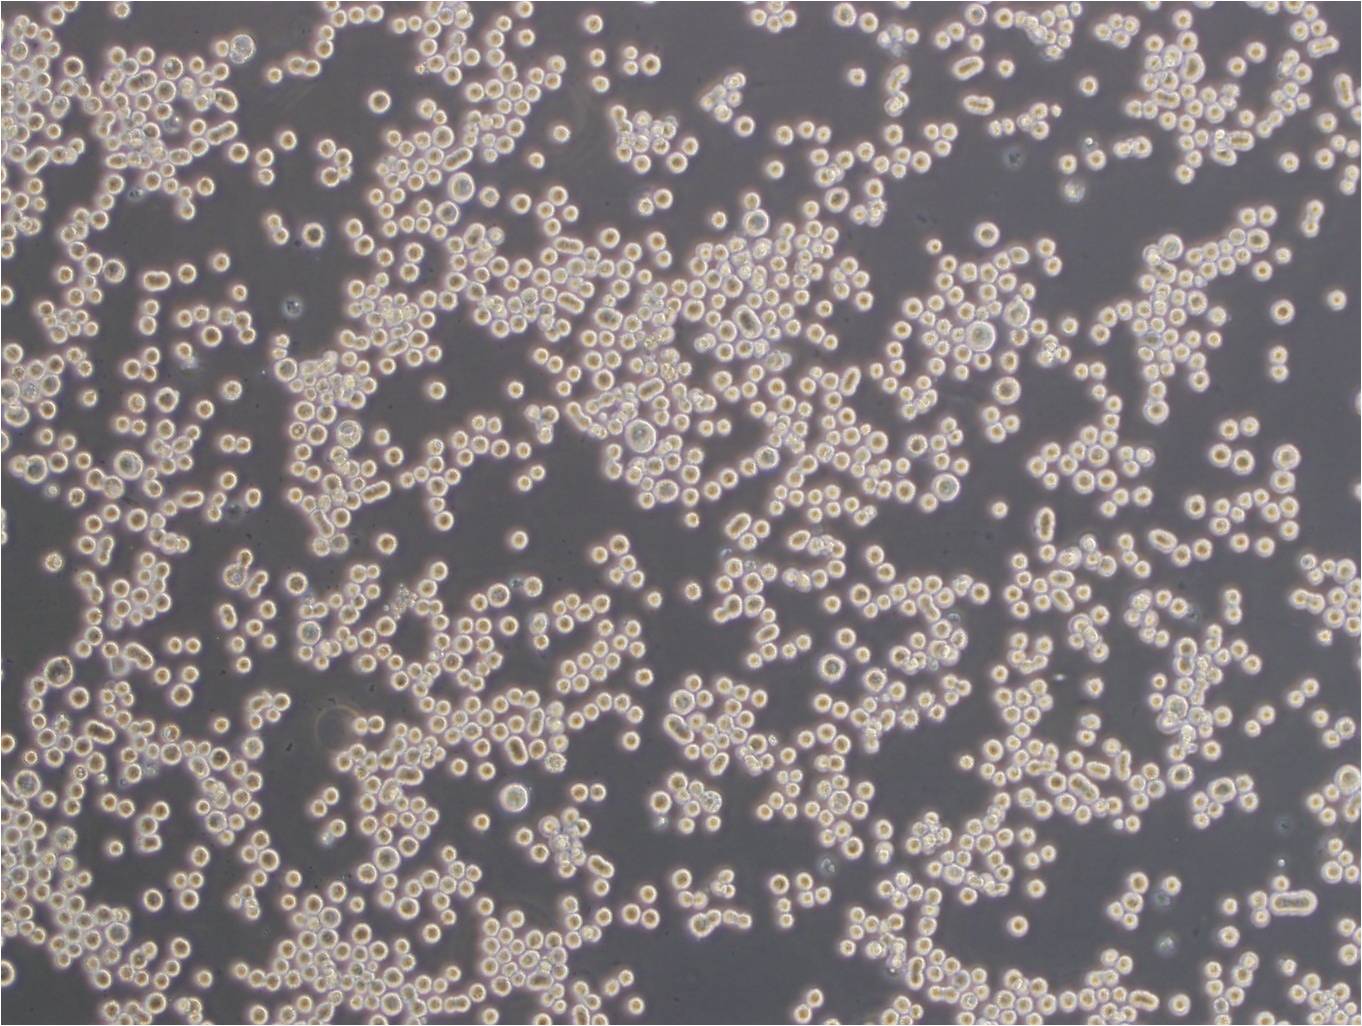
Anti-CD1A:T淋巴细胞CD1A抗体

"Anti-CD1A:T淋巴细胞CD1A抗体
保存条件:保存在4℃(短期)或-20℃(长期)
形态:Liquid
亚型:IgG等
英文名称:Anti-CD1A
应用范围:ELISA,WB,IHC,IP,FC,IF等
规格:100ul///200ul
宿主:Rabbit or Mouse等
适应物种:Human,Mouse,Rat等
阳离子转运调控样蛋白1抗体,英文名称:Anti-CHAC1,保存条件:保存在4℃(短期)或-20℃(长期),形态:Liquid,亚型:IgG等,应用范围:ELISA,WB,IHC,IP,FC,IF等,规格:100ul///200ul,宿主:Rabbit or Mouse等,适用物种:Human,Mouse,Rat等
SET结合蛋白1抗体,英文名称:Anti-SETBP1,保存条件:保存在4℃(短期)或-20℃(长期),形态:Liquid,亚型:IgG等,应用范围:ELISA,WB,IHC,IP,FC,IF等,规格:100ul///200ul,宿主:Rabbit or Mouse等,适用物种:Human,Mouse,Rat等
DCST1蛋白抗体,英文名称:Anti-DCST1,保存条件:保存在4℃(短期)或-20℃(长期),形态:Liquid,亚型:IgG等,应用范围:ELISA,WB,IHC,IP,FC,IF等,规格:100ul///200ul,宿主:Rabbit or Mouse等,适用物种:Human,Mouse,Rat等
有丝分裂控制样蛋白DIS3L抗体,英文名称:Anti-DIS3L,保存条件:保存在4℃(短期)或-20℃(长期),形态:Liquid,亚型:IgG等,应用范围:ELISA,WB,IHC,IP,FC,IF等,规格:100ul///200ul,宿主:Rabbit or Mouse等,适用物种:Human,Mouse,Rat等
有丝分裂检验点蛋白BubR1抗体,英文名称:Anti-BubR1,保存条件:保存在4℃(短期)或-20℃(长期),形态:Liquid,亚型:IgG等,应用范围:ELISA,WB,IHC,IP,FC,IF等,规格:100ul///200ul,宿主:Rabbit or Mouse等,适用物种:Human,Mouse,Rat等
唾液酸转移酶1/α-2,6唾液酸转移酶抗体,英文名称:Anti-CD75,保存条件:保存在4℃(短期)或-20℃(长期),形态:Liquid,亚型:IgG等,应用范围:ELISA,WB,IHC,IP,FC,IF等,规格:100ul///200ul,宿主:Rabbit or Mouse等,适用物种:Human,Mouse,Rat等
蛋白偶联受体70抗体,英文名称:Anti-GPR70/T1R1,保存条件:保存在4℃(短期)或-20℃(长期),形态:Liquid,亚型:IgG等,应用范围:ELISA,WB,IHC,IP,FC,IF等,规格:100ul///200ul,宿主:Rabbit or Mouse等,适用物种:Human,Mouse,Rat等
磷酸化细胞周期末期促进复合蛋白APC1抗体,英文名称:Anti-phospho-ANAPC1 (Ser355),保存条件:保存在4℃(短期)或-20℃(长期),形态:Liquid,亚型:IgG等,应用范围:ELISA,WB,IHC,IP,FC,IF等,规格:100ul///200ul,宿主:Rabbit or Mouse等,适用物种:Human,Mouse,Rat等
线粒体裂变调节蛋白1抗体,英文名称:Anti-MTFR1,保存条件:保存在4℃(短期)或-20℃(长期),形态:Liquid,亚型:IgG等,应用范围:ELISA,WB,IHC,IP,FC,IF等,规格:100ul///200ul,宿主:Rabbit or Mouse等,适用物种:Human,Mouse,Rat等
驱动蛋白KIF5B抗体,英文名称:Anti-KLF5/UKHC,保存条件:保存在4℃(短期)或-20℃(长期),形态:Liquid,亚型:IgG等,应用范围:ELISA,WB,IHC,IP,FC,IF等,规格:100ul///200ul,宿主:Rabbit or Mouse等,适用物种:Human,Mouse,Rat等
LRIG1抗体,英文名称:Anti-LRIG1,保存条件:保存在4℃(短期)或-20℃(长期),形态:Liquid,亚型:IgG等,应用范围:ELISA,WB,IHC,IP,FC,IF等,规格:100ul///200ul,宿主:Rabbit or Mouse等,适用物种:Human,Mouse,Rat等
组蛋白赖氨酸特异性脱甲基酶1抗体,英文名称:Anti-KDM1,保存条件:保存在4℃(短期)或-20℃(长期),形态:Liquid,亚型:IgG等,应用范围:ELISA,WB,IHC,IP,FC,IF等,规格:100ul///200ul,宿主:Rabbit or Mouse等,适用物种:Human,Mouse,Rat等
磷酸脂磷酸水解酶2抗体,英文名称:Anti-PPAP2C,保存条件:保存在4℃(短期)或-20℃(长期),形态:Liquid,亚型:IgG等,应用范围:ELISA,WB,IHC,IP,FC,IF等,规格:100ul///200ul,宿主:Rabbit or Mouse等,适用物种:Human,Mouse,Rat等
白细胞介素-12受体β2抗体,英文名称:Anti-IL12RB2,保存条件:保存在4℃(短期)或-20℃(长期),形态:Liquid,亚型:IgG等,应用范围:ELISA,WB,IHC,IP,FC,IF等,规格:100ul///200ul,宿主:Rabbit or Mouse等,适用物种:Human,Mouse,Rat等
人水痘带状疱疹病毒gE蛋白抗体,英文名称:Anti-membrane glycoprotein E(VZV),保存条件:保存在4℃(短期)或-20℃(长期),形态:Liquid,亚型:IgG等,应用范围:ELISA,WB,IHC,IP,FC,IF等,规格:100ul///200ul,宿主:Rabbit or Mouse等,适用物种:Human,Mouse,Rat等
脱氧核糖核酸酶2抗体,英文名称:Anti-DNase II,保存条件:保存在4℃(短期)或-20℃(长期),形态:Liquid,亚型:IgG等,应用范围:ELISA,WB,IHC,IP,FC,IF等,规格:100ul///200ul,宿主:Rabbit or Mouse等,适用物种:Human,Mouse,Rat等
尿激酶型纤溶酶原激活因子抗体,英文名称:Anti-PLAU/UPA/Urokinase,保存条件:保存在4℃(短期)或-20℃(长期),形态:Liquid,亚型:IgG等,应用范围:ELISA,WB,IHC,IP,FC,IF等,规格:100ul///200ul,宿主:Rabbit or Mouse等,适用物种:Human,Mouse,Rat等
钠钙交换蛋白2抗体,英文名称:Anti-NCX2/SLC8A2,保存条件:保存在4℃(短期)或-20℃(长期),形态:Liquid,亚型:IgG等,应用范围:ELISA,WB,IHC,IP,FC,IF等,规格:100ul///200ul,宿主:Rabbit or Mouse等,适用物种:Human,Mouse,Rat等
血型Lewis a抗体,英文名称:Anti-Blood Group Lewis a,保存条件:保存在4℃(短期)或-20℃(长期),形态:Liquid,亚型:IgG等,应用范围:ELISA,WB,IHC,IP,FC,IF等,规格:100ul///200ul,宿主:Rabbit or Mouse等,适用物种:Human,Mouse,Rat等
FbxW2蛋白抗体,英文名称:Anti-FbxW2,保存条件:保存在4℃(短期)或-20℃(长期),形态:Liquid,亚型:IgG等,应用范围:ELISA,WB,IHC,IP,FC,IF等,规格:100ul///200ul,宿主:Rabbit or Mouse等,适用物种:Human,Mouse,Rat等
自噬相关蛋白3抗体,英文名称:Anti-ATG3,保存条件:保存在4℃(短期)或-20℃(长期),形态:Liquid,亚型:IgG等,应用范围:ELISA,WB,IHC,IP,FC,IF等,规格:100ul///200ul,宿主:Rabbit or Mouse等,适用物种:Human,Mouse,Rat等
人乙型肝炎e抗原单克隆抗体(1),英文名称:Anti-HBeAg(2E9),保存条件:保存在4℃(短期)或-20℃(长期),形态:Liquid,亚型:IgG等,应用范围:ELISA,WB,IHC,IP,FC,IF等,规格:100ul///200ul,宿主:Rabbit or Mouse等,适用物种:Human,Mouse,Rat等
转化蛋白p21抗体(原癌基因H-ras抗体),英文名称:Anti-HRAS+KRAS,保存条件:保存在4℃(短期)或-20℃(长期),形态:Liquid,亚型:IgG等,应用范围:ELISA,WB,IHC,IP,FC,IF等,规格:100ul///200ul,宿主:Rabbit or Mouse等,适用物种:Human,Mouse,Rat等
DISC1 N端抗体,英文名称:Anti-DISC1(NT),保存条件:保存在4℃(短期)或-20℃(长期),形态:Liquid,亚型:IgG等,应用范围:ELISA,WB,IHC,IP,FC,IF等,规格:100ul///200ul,宿主:Rabbit or Mouse等,适用物种:Human,Mouse,Rat等
脑特异性血管生成抑制蛋白2抗体,英文名称:Anti-BAI2/Brain Specific Angiogenesis Inhibitor 2,保存条件:保存在4℃(短期)或-20℃(长期),形态:Liquid,亚型:IgG等,应用范围:ELISA,WB,IHC,IP,FC,IF等,规格:100ul///200ul,宿主:Rabbit or Mouse等,适用物种:Human,Mouse,Rat等
宫颈癌原癌基因8抗体,英文名称:Anti-TTC23,保存条件:保存在4℃(短期)或-20℃(长期),形态:Liquid,亚型:IgG等,应用范围:ELISA,WB,IHC,IP,FC,IF等,规格:100ul///200ul,宿主:Rabbit or Mouse等,适用物种:Human,Mouse,Rat等
表皮生长因子抗体(小鼠),英文名称:Anti-EGF(mouse),保存条件:保存在4℃(短期)或-20℃(长期),形态:Liquid,亚型:IgG等,应用范围:ELISA,WB,IHC,IP,FC,IF等,规格:100ul///200ul,宿主:Rabbit or Mouse等,适用物种:Human,Mouse,Rat等
血小板源性生长因子受体β样蛋白抗体,英文名称:Anti-PDGFRL,保存条件:保存在4℃(短期)或-20℃(长期),形态:Liquid,亚型:IgG等,应用范围:ELISA,WB,IHC,IP,FC,IF等,规格:100ul///200ul,宿主:Rabbit or Mouse等,适用物种:Human,Mouse,Rat等
磷酸相互作用结构域蛋白1抗体,英文名称:Anti-PID1,保存条件:保存在4℃(短期)或-20℃(长期),形态:Liquid,亚型:IgG等,应用范围:ELISA,WB,IHC,IP,FC,IF等,规格:100ul///200ul,宿主:Rabbit or Mouse等,适用物种:Human,Mouse,Rat等
21号染色体开放阅读框128抗体,英文名称:Anti-C21orf128,保存条件:保存在4℃(短期)或-20℃(长期),形态:Liquid,亚型:IgG等,应用范围:ELISA,WB,IHC,IP,FC,IF等,规格:100ul///200ul,宿主:Rabbit or Mouse等,适用物种:Human,Mouse,Rat等
"